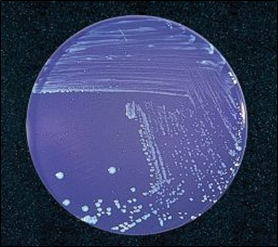

EL MÉTODO P/A (PRESENCIA AUSENCIA) Y RECUENTO NMP MEDIANTE LOS KITS P/A DE MICROKIT PARA TODOS LOS PARÁMETROS. NMP-RACKS
1- POTABILIDAD MICROBIOLOGICA DE LAS AGUAS MEDIANTE EL METODO DE PRESENCIA/AUSENCIA (Kits preparados sin necesidad de Filtración de Membrana ni de Número Más Probable)
Extraído de la Directiva Europea sobre aguas de consumo humano, (obligada desde el 3/XI/2001, y sobre todo desde su transcripción a B.O.E. 45 de fecha 21/2/2003).
Esta Normativa, además de afectar a las aguas potables y envasadas, también afecta a todas las aguas de uso en industrias alimentarias, para producción, lavado, etc.:
TIPO DE ANÁLISIS PARÁMETRO NIVEL GUIA KIT P/A MICROKIT

Desde la publicación de estos datos, la técnica MPN para controlar la potabilidad de aguas queda obsoleta, quedando relegada sólo a recuento en productos no filtrables;
en efecto, al hablar la legislación de ausencia en 100 ml no se puede utilizar la técnica de MPN y extrapolar resultados a partir de una muestra significativamente inferior (33 ml) a los 100 ml requeridos.
Los recuentos en 100 ml pueden realizarse con la técnica de MF, pero en el caso que nos ocupa podemos utilizar las MPN-RACKS (Ref: 1001020) para convertir cualquier kit P/A en Número Más Probable.
Por todo ello surge con fuerza la nueva técnica de Presencia /Ausencia (P/A), útil tanto para trabajo de campo como para Laboratorio, cuando lo que se precisa no es recuento, sino detección de un microorganismo en grandes muestras.
Todos los kits P/A de MICROKIT en frascos preparados incorporan inactivadores de la eventual presencia de cloro en el agua, que actuaría como bacteriostático y enmascararía los resultados como falsos negativos.
El método P/A es mucho más sensible (tienen muchos menos falsos negativos) que el método MF, pero es menos específico (tienen más falsos positivos).
Por ello es tan útil como screening negativo, para poder procesar un gran número de muestras.
Si el kit da negativo, el resultado es negativo y no hace falta hacer nada más.
Y si el kit sale positivo, hay que confirmar esa muestra estriando en placa e identificando colonias aisladas.
Nuestros kits están validados para uso en aguas continentales, no marinas ni salinas.
NOTA: Para analizar agua de mar, se debe diluir ésta a razón 1:10 en agua destilada estéril, ya que la salinidad del mar (3,7-4,5%) sería excesiva para los kits.
Todos nuestros kits P/A permiten ahorrar 4-8 horas de incubación si, antes de inocularlos, se precalienta a 37°C la muestra de agua en un baño María.
EL MÉTODO P/A (PRESENCIA AUSENCIA) Y RECUENTO NMP MEDIANTE LOS KITS P/A DE MICROKIT PARA TODOS LOS PARÁMETROS. NMP-RACKS
1-A KIT P/A DE DETECCION DE COLIFORMES (TOTALES Y/O FECALES) Y E.COLI EN 100 ml DE AGUA (Caldo MICROKIT® P/A MCC-COLICULT ®  Cromofluorogénico) Referencia: RPL303
Cromofluorogénico) Referencia: RPL303
La legislación española (BOE 21/2/03) exige la ausencia de E.coli y de Coliformes totales en 100 ml de agua de consumo humano (la clásica potable y además la de uso en industria alimentaria).
Las dos posibilidades contempladas hasta ahora para este análisis (Número Más Probable ‑NMP‑ y Filtración de Membrana ‑FM‑) eran tediosas en su manipulación (9 tubos la primera, aparato de filtración la segunda)
y los resultados obtenidos en Coliformes implicaban un alto porcentaje de resultados falsamente negativos (18 % en el primer caso y 36 % en el segundo
según JACOBS & Co., Mayo ’86, Comparison of Membrane Filter, Multiple Fermentation Tube and Presence/Absense (P/A) Techniques for detecting Total Coliforms in Small Community Water Systems, App. Env. Microbiol., Vol. 51, n.º 5, pp. 1007-1012).
Con el nuevo método de Presencia/Ausencia, que ya es oficial en U.S.A., el porcentaje de falsos negativos se reduce considerablemente,
ya que la muestra es de 100 ml (muy superior que en la técnica NMP) y las bacterias no sufren como en la técnica de FM.
Además de su mayor sensibilidad, el método P/A es el más cómodo de inocular y el más simple de interpretar.
Cada vez son más los autores que coinciden en que no hay mejor parámetro indicador de la contaminación fecal de las aguas que la especie Escherichia coli.
Efectivamente, las enterobacterias son un grupo demasiado extenso que contiene muchos representantes naturales en las aguas, que no indican contaminación fecal.
Y los coliformes también cuentan con especies naturales en las aguas, además de ser un grupo artificial (hay especies como el mismo E. coli con cepas que son coliformes y con cepas que al no producir gas al fermentar la lactosa, ni tener galactosidasa, no son coliformes).
Su división en coliformes totales y coliformes fecales (parámetro éste más selectivo) no resolvía totalmente el problema.
Por ello el kit de Coliformes y E. coli P/A resulta de gran interés para análisis de potabilidad como parámetro más estricto que el descrito en la legislación anterior a Febrero de 2003,
y cumple perfectamente con la nueva legislación, al haberse validado en ensayos intercolaborativos y en el intercomparativo SEILAGUA, realizados en España durante 1999-2003,
donde demuestra un 10% más de sensibilidad (escasez de falsos negativos) que el método MF para el parámetro E.coli.
El kit se basa en la moderna y reconocida técnica del MUG, o fluorescencia indicadora de E. coli.
Se incuba a 35 ó 44,5 ºC (según se busquen, además de E. coli, coliformes totales o fecales, respectivamente) durante sólo 24 (-48) horas.
Y del X-Gal que hace que los coliformes viren el agua a azul turquesa a aprtir de la fermentación del sorbitol, con lo cual no se escapan los coliformes lactosa negativos.
Haya o no coliformes (hay cepas de E. coli que no fermentan la lactosa ni el sorbitol ni, por tanto, pueden considerarse coliformes strictu sensu), observar en la oscuridad completa con luz U.V.A. de 366 nm (linterna MICROKIT).
Si aparece fluorescencia azul claro (comparar con un control positivo -kit inoculado con cepa de E. coli– y con un control negativo -kit inoculado con agua estéril-), añadir 1 ml de reactivo de Indol Kovacs (MICROKIT SBH056).
Si tras unos segundos aparece en superficie un anillo de color rojo-cereza, la presencia de E. coli es absolutamente confirmativa, por lo que no son necesarias identificaciones posteriores.
Como control positivo puede utilizarse la cepa E. coli en cómodas lentículas de MICROKIT.
Recomendamos asimismo la participación en servicios intercomparativos como SEILAGUAS FARMACOSMÉTICAS, para validar los procedimientos y los operarios.
MODO DE EMPLEO
- Añadir 100 ml de agua de muestra abriendo el tapón o bien pinchando en el obturador.
- Cerrar el tapón sin apretar a fondo (para que escape el exceso de gas que se pueda generar).
- Agitar para mezclar.
- Incubar en posición vertical a 35 ºC 0,5 durante 24‑48 horas.
- Si se buscan específicamente Coliformes fecales, incubar a 44,5 ºC (aunque si no había Coliformes totales, lógicamente tampoco habrá Coliformes fecales).
INTERPRETACION DE RESULTADOS
Observar la producción de turbidez (crecimiento bacteriano inespecífico),
el viraje del medio incoloro a azul (reacción positiva ONPG-XGal, típica de los coliformes)
y la fluorescencia en la oscuridad con luz ultravioleta de 366 nm (reacción positiva del MUG, típica de E.coli).
En este último caso añadir unas gotas de Kovacs (SBH056) directamente, para confirmar E.coli (formación de anillo rojo) con la prueba del indol.
PRESENTACION
Cajas con 10 frascos. Caducidad desde fabricación: 1 año.
Conservar entre 4 y 25 ºC, en la oscuridad.
Este kit sustituye, desde principios de 1998, al antiguo RPL303 de Coliformes + E.coli con campana Durham y al antiguo RPL300 de Coliformes totales + Coliformes Fecales con campana Durham.
Validación: Realizada durante 7 años de intercomparación de 70 laboratorios de toda España en más de 700 muestras duplicadas.
Se demuestra comparado con filtración de membrana en el medio oficial (Tergitol Chapman TTC Agar), una sensibilidad del 100% frente al 97,7% del método oficial para coliformes, así como una sensibilidad del 100% para E.coli frente al 95,65% del método oficial.
Una especificidad del 100% para coliformes frente al 94,25% del método oficial y del 100% para E.coli frente al 94,57% del método oficial.
Y un límite de detección de hasta 3±2 ufc/100 ml frente a 5±2 ufc/100 ml del método oficial.
Si analiza muchas muestras al día, vea las versiones viales P/A y Botes P/A.
EL MÉTODO P/A (PRESENCIA AUSENCIA) Y RECUENTO NMP MEDIANTE LOS KITS P/A DE MICROKIT PARA TODOS LOS PARÁMETROS. NMP-RACKS
1-B KIT AUXILIAR PARA RECUENTO TOTAL EN 1 ml DE AGUA: TUBOS NUTRIENT AGAR TTC + PLACAS Petri (Agar Nutritivo TTC, Agar Común TTC) Referencia: RPL305
Según el B.O.E. 226 de 20/09/90, en un agua potable no han de aparecer más de 10 bacterias aerobias por mililitro (incubando a 37 ºC) ni más de 100 bacterias aerobias por mililitro (incubado a 22 ºC).
El recuento en 1 ml puede realizarse con la técnica MF (MICROKIT UFM006, UFM012), pero resulta más lógico utilizar la técnica tradicional como en alimentos,
dado que la técnica MF encuentra sus ventajas cuando el tamaño de la muestra es muy superior a 1 ml (de hecho, si se utiliza MF para 1 ml hay que añadir al menos 25 ml de Agua Peptonada estéril para que la filtración sea homogénea en toda la membrana).
Con el Kit que presentamos, Ud. ya no necesita autoclavar medios deshidratados, ni realizar recuentos aproximados.
El medio esta estéril y listo para su empleo, y el recuento es exacto.
Las colonias crecen rojas sobre el medio, blanquecino. No hace falta tratar la muestra contra el cloro, el medio ya incorpora Tiosulfato Sódico.
La caducidad de 2 años, permite mantener un stock sin riesgo de echar a perder reactivos, ventaja importante sobre las placas preparadas.
Para seguir más estrictamente el BOE 21/2/2003 (ISO 6222) usar tubos de Yeast Extract Agar (TPL060).
MODO DE EMPLEO E INTERPRETACION DE RESULTADOS
- Fundir 2 tubos al Baño María (98 ºC aproximadamente). No sobrecalentar o el medio virará a rosa-rojo.
- Añadir 1 ml de agua de muestra en una placa Petri estéril. Duplicar la operación.
- Trabajar junto a la llama de un mechero para conseguir unas condiciones asépticas en el ambiente.
- Verter el contenido de un tubo (atemperado hasta que no queme la mano), a una de las placas con muestra. Duplicar la operación en la otra placa con muestra.
- Cerrar las placas y hacerlas girar 10 veces en cada sentido para mezclar la muestra con el medio. Dejar solidificar.
- Incubar las placas con el agar arriba, una a 37 ºC durante 24 horas y otra a 22 ºC durante 72 horas.
- Contar todas las colonias, que habrán virado a rojo, contrastando estupendamente con el medio de cultivo y haciendo el recuento sumamente fácil.
- No deben aparecer más de 10 colonias en la primera placa, ni más de 100 en la segunda.
PRESENTACION
Kits de 40 tubos + 40 placas para 20 análisis dobles de recuento total en 1 ml de agua. Caducidad desde fabricación: 1 año. Conservar entre 2 y 25 ºC, en la oscuridad.
Como control positivo puede utilizarse una cepa de E.coli (CRIOSTRAIN MKTA 25922) o de
Como control positivo puede utilizarse la cepa E. coli, de Pseudomonas aeruginosa y/o de Enterococcus faecalis en cómodas lentículas de MICROKIT.
Recomendamos asimismo la participación en servicios intercomparativos como SEILAGUAS FARMACOSMÉTICAS, para validar los procedimientos y los operarios.
Material necesario no incluido: Estufa a 35-37 ºC (VRP001), Pipetas estériles 1 ml (VFR273), Zona aséptica:
Si no dispone de cabina de flujo laminar, puede usar el Portabunsen de MICROKIT.
NOTA: Desde la creación de las DryPlates®-TC-Water,
estas plaquitas resultan mucho más adecuadas para recuento total en 1 ml de agua porque absorben directamente el ml de muestra de agua sin necesidad de fundir medios como sucede en el método clásico, incluido el kit mencionado arriba.
Los resultados de la validación para aguas no pueden ser más alentadores y demuestran que la siembra por fusión en masa de agares calientes es un punto crítico más importante de lo que se cree.
Nos remitimos al folleto de las DryPlates®-TC y al certificado de validación intercolaborativa de Microkit sobre las mismas.
EL MÉTODO P/A (PRESENCIA AUSENCIA) Y RECUENTO NMP MEDIANTE LOS KITS P/A DE MICROKIT PARA TODOS LOS PARÁMETROS. NMP-RACKS
1-C KIT P/A PARA LA DETECCION DE ENTEROCOCOS FECALES GRUPO D DE LANCEFIELD EN 100 ml DE AGUA (ENTEROCULT MICROKIT® P/A modificado) Ref: RPL301 
Bilis Aesculina Azida (BEA) es un medio ISO para detección de enterococos fecales en muestras de aguas.
Aplicado a la concentración adecuada, y con ciertas modificaciones (pasarlo de agar a caldo), permite la utilización en kits P/A.
MODO DE EMPLEO
- Añadir 100 ml del agua de muestra.
- Cerrar sin apretar a fondo.
- Agitar para mezclar.
- Incubar a 37 ºC (41°C) durante 24‑48 horas.
Como control positivo puede utilizarse la cepa Enterococcus faecalis en cómodas lentículas de MICROKIT.
Recomendamos asimismo la participación en servicios intercomparativos como SEILAGUAS FARMACOSMÉTICAS, para validar los procedimientos y los operarios.
INTERPRETAClON DE RESULTADOS
La aparición de turbidez con ennegrecimiento indica que la muestra tiene estreptococos fecales, sobre todo si el medio pierde su fluorescencia natural bajo luz de 366 nm (linterna MICROKIT). Además se vuelve opaco.
PRESENTACION: Cajas con 10 frascos. Caducidad desde fabricación: 1 año.
Conservar entre 2 y 25 ºC, en la oscuridad.
Validación: Realizada durante 7 años de intercomparación de 70 laboratorios de toda España en más de 700 muestras duplicadas.
Se demuestra comparado con filtración de membrana en el medio oficial para enterococos fecales (Slanetz-Bartley Agar + Bilis Esculina Azida Agar), una sensibilidad del 100% frente al 95,6% del método oficial.
Una especificidad del 100% frente al 61,0% del método oficial.
Y un límite de detección coincidente en ambos métodos.
Si analiza muchas muestras al día, vea las versiones viales P/A y Botes P/A.
EL MÉTODO P/A (PRESENCIA AUSENCIA) Y RECUENTO NMP MEDIANTE LOS KITS P/A DE MICROKIT PARA TODOS LOS PARÁMETROS. NMP-RACKS
1-D KIT AUXILIAR PARA RECUENTO DE CLOSTRIDIOS SULFITO REDUCTORES EN 20‑50 ml DE AGUA (Agar SPS parafinado modificado concentrado) Referencia: RPL062
Los anaerobios no crecen muy bien con el método de Filtración de Membrana (MICROKIT UFM014, UFM011) y el método P/A no es válido en muchas legislaciones, que admiten 1 UFC de Clostridio Sulfito-Reductor en 20-50 ml de agua.
Por ello, hemos diseñado un kit especialmente preparado para poder realizar recuento y P/A en muestras de gran volumen (hasta 50 ml).
MODO DE EMPLEO E INTERPRETACION DE RESULTADOS:
- Fundir al Baño María a 98 ºC.
- Inocular en profundidad, mediante una pipeta caliente, los 20-50 ml de agua de muestra calentada a 75 ºC (si la parafina solidifica antes de sacar la pipeta, recalentar el conjunto a 75 ºC durante el mínimo tiempo necesario para que la parafina vuelva a licuar).
- El shock térmico elimina las formas vegetativas y activa la germinación de las esporas.
- Voltear sin agitar para mezclar sin airear el medio, una sola vez.
- Incubar a 35‑37 ºC durante 24‑48 horas.

PRESENTACION: Cajas con 10 frascos. Caducidad desde fabricación: 1 año.
Como todos los kits para anaerobios, NO debe guardarse en nevera, para impedir que el medio se oxigene con el frío.
Conservar a 21-25 ºC, en la oscuridad.
Como control positivo puede utilizarse la cepa Clostridium perfringens en cómodas lentículas de MICROKIT.
Recomendamos asimismo la participación en servicios intercomparativos como SEILAGUAS FARMACOSMÉTICAS, para validar los procedimientos y los operarios.
NUEVO KIT:
Emplee Quanti-P/A Clostricult para detección y recuento de Clostridium perfringens con TSC (o bien de Clostridium sulfito redutores con SPS) y sus esporas, sin neesidad de alentar medios.
EL MÉTODO P/A (PRESENCIA AUSENCIA) Y RECUENTO NMP MEDIANTE LOS KITS P/A DE MICROKIT PARA TODOS LOS PARÁMETROS. NMP-RACKS
1-E KIT PARA P/A DE CLOSTRIDIUM PERFRINGENS Y SUS ESPORAS CLOSTRICULT MICROKIT® P/A Referencia: RPL 308 
Elaborado a partir de caldo TSC (CLOSTRICULT-2) para adaptarse a las optimizaciones observadas mediante los servicios SEILAGUA®, desde Octubre de 2005, se optimiza de nuevo en Mayo 2007 para facilitar la anaerobiosis con más agentes reductores y con parafina líquida.
Añadir 100 ml de agua de muestra, dejando una cámara de aire de 5 cm de altura.
Cerrar el tapón sin apretar a fondo.
Voltear sin agitar, para mezclar sin oxigenar.
Incubar a (37 ºC) 44-46 ºC durante 18-48-(72) horas.
Si busca sólo esporas, realizar un shock térmico de 5-10 minutos a 86 ºC.
El viraje a negro (que suele expandirse de abajo arriba) a 44-46 ºC indica presencia de Clostridium perfringens (o de sus esporas si se realizó shock térmico).
El viraje a negro a 37 ºC indica sólamente presencia de Clostridios sulfito-reductores (o de sus esporas si se realizó shock térmico).
Como control positivo puede utilizarse la cepa Clostridium perfringens en cómodas lentículas de MICROKIT.
Recomendamos asimismo la participación en servicios intercomparativos como SEILAGUAS FARMACOSMÉTICAS, para validar los procedimientos y los operarios.
El usuario final es el único responsable de la destrucción de los microorganismos que se hayan multiplicado en el interior de cada tubo o frasco, de acuerdo con la legislación medioambiental vigente.
Añada cloro o lejía hasta el borde con cuidado de no tocar ni derramar el cultivo (si al abrir los botes sale gas a presión o líquido, lavar bien las manos con agua corriente y jabón), o bien autoclavar, antes de desechar a la basura.
Validación: Realizada durante 7 años de intercomparación de 70 laboratorios de toda España en más de 700 muestras duplicadas.
Se demuestra comparado con filtración de membrana en el medio oficial para Clostridium perfringens y sus esporas (mCP Agar y también frente a TSC Agar), una sensibilidad del 77,3 % frente al 14,33% del método oficial y al 56,0% del TSC.
Una especificidad del 100% frente al 100% del método oficial y del 95,8% del TSC.
Y un límite de detección de 3 a 10 veces más cercano a 1 ufc/100 ml que el método oficial: 2±1 ufc/100 ml con un 85% de detecciones frente a 8±7 ufc/100 ml en TSC Agar con sólo un 40% de detecciones.
Si analiza muchas muestras al día, vea las versiones viales P/A y Botes P/A de polvo estéril.
2- EL METODO MICROKIT® P/A PARA OTROS PARAMETROS (Kits preparados sin necesidad de Filtración de Membrana ni de número Más Probable)
Además del parámetro de POTABILIDAD en las aguas, existen otros de gran importancia en la industria y medio ambiente.
Presentamos los kits P/A diseñados especialmente para todos ellos.
Todos cuentan con 1 año de caducidad desde fabricación en frascos preparados, se presentan en cajas de 10 unidades e incorporan inactivadores de la eventual presencia de cloro en el agua.
Si analiza muchas muestras al día, vea las versiones viales P/A y Botes P/A de polvo estéril.
Se almacenan entre 2 y 25 ºC al abrigo de la luz.
El modo de empleo también es común a todos ellos: Añadir hasta 100 ml del agua o del líquido de muestra, agitar e incubar.
Se describen a continuación la utilidad, las condiciones de incubación y la interpretación de resultados de todos ellos:
EL MÉTODO P/A (PRESENCIA AUSENCIA) Y RECUENTO NMP MEDIANTE LOS KITS P/A DE MICROKIT PARA TODOS LOS PARÁMETROS. NMP-RACKS
2-A MICROKIT® P/A PARA LA DETECCION DE PSEUDOMONAS sp. (Y AEROMONAS / PLESIOMONAS) EN 100 ml DE AGUA (Caldo GSP modificado) Referencia: RPL309
La presencia de estos microorganismos es indicadora de infiltración de aguas naturales, residuales o no, y puede provocar la formación de limos obstructores de circuitos.
En ciertos países, como Holanda, la legislación exige la ausencia de Aeromonas en las aguas potables.
La aparición de Pseudomonas diminuta en aguas filtradas por 0,22 µm implica la rotura de los filtros.
Además distintas especies como Pseudomonas aeruginosa son patógenas para el hombre;
ciertas especies de Aeromonas son patógenos animales muy indeseables en piscifactorías:
y algunas cepas de Aeromonas hydrophila han provocado enfermedad en el hombre;
y Plesiomonas shigelloides provoca en el hombre cuadros gastroenteríticos similares a los de Shigella o Vibrio.
Este kit es útil para análisis de aguas purificadas en laboratorios cercanos al mar, a cauces de ríos y lagos, a pozos…, así como para análisis de aguas de piscinas y playas, aguas de barcos, acuicultura, etc.
El kit se incuba a 30-37 ºC durante 24-72 horas.
El viraje a naranja o amarillo es indicador presuntivo de Aeromonas/Plesiomonas.
El viraje a azulado o violáceo es indicador presuntivo de especies de Pseudomonas.
Cualquier turbidez sin viraje es sospechosa.
Turbidez y/o viraje deben confirmarse sembrando una gota del líquido del kit en la superficie de una placa de GSP Agar (MICROKIT DMT148) e identificando las colonias crecidas (MICROKIT KBH262).
Como control positivo puede utilizarse la cepa Pseudomonas aeruginosa en cómodas lentículas de MICROKIT.
Recomendamos asimismo la participación en servicios intercomparativos como SEILAGUAS FARMACOSMÉTICAS, para validar los procedimientos y los operarios.
EL MÉTODO P/A (PRESENCIA AUSENCIA) Y RECUENTO NMP MEDIANTE LOS KITS P/A DE MICROKIT PARA TODOS LOS PARÁMETROS. NMP-RACKS
2-B MICROKIT® P/A PSEUDOCULT PARA LA DETECCION DE PSEUDOMONAS AERUGINOSA EN 100 ml DE AGUA (Caldo Cetrimida altamente selectivo y muy modificado, con cromógenos)
Referencia: RPL302 
Este patógeno debe estar ausente en el agua de cualquier laboratorio, sobre todo si es de una fábrica de medicamentos o productos cosméticos, de aguas envasadas o en quirófanos y uvis en los hospitales.
El frasco se cierra, se pincha en la parte elástica del tapón una aguja provista de filtro y se introduce a incubar en estufa a 37±1ºC de 18 horas a 5 días.
El viraje a rosa en 18-24h, con fluorescencia en 48h bajo luz UVA de 366 nm (linterna MICROKIT VMT050) es altamente presuntivo de Pseudomonas aeruginosa, aunque tras las 48h puede virar a rojo.
El viraje a salmón es presuntivo de Burkholderia cepacia.
Un viraje a rojo intenso, opaco y rápido (24h), puede ser ocasionado por E.coli y, en aguas marinas, por ciertas especies de Aeromonas y de Vibrio.
Debe confirmarse aislando colonias, estriando en Agar Cetrimida (MICROKIT DMT034, PPL011, TPL100, RPL010) e identificando las mismas (MICROKIT 245000).
Como control positivo puede utilizarse la cepa Pseudomonas aeruginosa en cómodas lentículas de MICROKIT.
Recomendamos asimismo la participación en servicios intercomparativos como SEILAGUAS FARMACOSMÉTICAS, para validar los procedimientos y los operarios.
La validación interna del kit demuestra su excelente capacidad de detección, que resulta incluso del 100% de sensibilidad para inóculos de 1-2 ufc de P.aeruginosa/100-250 ml de agua, lo cual es un límite de detección inmejorable.
En 7 años de intercomparación de 70 laboratorios de toda España en más de 700 muestras duplicadas, se demuestra comparado con filtración de membrana en el medio oficial (Cetrimida CN Agar) una sensibilidad y una especificidad del 100% frente al 73,4% y al 91,3% respectivamente del método oficial,
así como un límite de detección 50 veces más cercano a 1 ufc/100 ml que el método oficial.
Si analiza muchas muestras al día, vea las versiones viales P/A y Botes P/A.
EL MÉTODO P/A (PRESENCIA AUSENCIA) Y RECUENTO NMP MEDIANTE LOS KITS P/A DE MICROKIT PARA TODOS LOS PARÁMETROS. NMP-RACKS
2-B-BIS: MICROKIT® P/A PARA LA DETECCION DE BURKHOLDERIA CEPACIA EN 100 ml DE AGUA (Caldo BCPT selectivo, color anaranjado) Referencia: RPL323
 Este oportunista del biofilm del agua se detecta incubando el kit a 35 ºC durante 24 horas.
Este oportunista del biofilm del agua se detecta incubando el kit a 35 ºC durante 24 horas.
Sólo B.cepacia es capaz de crecer tan deprisa en este caldo cromogénico, provocando el viraje a rojo tinto.
Como siempre, confirme los positivos estriando en placa de agar selectivo e identificando las colonias (MICROKIT 245000).
A las 48-72 horas otros microorganismos pueden provocar falsos positivos con virajes tardíos del mismo tono.
Puede conseguir que el kit sea muy selectivo añadiendo a cada frasco 0,14 ml del suplemento SMT301.
Como control positivo puede utilizarse la cepa Burkholderia cepacia en cómodas lentículas de MICROKIT.
Recomendamos asimismo la participación en servicios intercomparativos como SEILAGUAS FARMACOSMÉTICAS, para validar los procedimientos y los operarios.
Si analiza muchas muestras al dia, vea las versiones viales P/A y Botes P/A.
EL MÉTODO P/A (PRESENCIA AUSENCIA) Y RECUENTO NMP MEDIANTE LOS KITS P/A DE MICROKIT PARA TODOS LOS PARÁMETROS. NMP-RACKS
2-C MICROKIT® P/A PARA LA DETECCION DE VIBRIO HALÓFILOS EN 100 ml DE AGUA (Caldo Alcalino HiperSalino MICROKIT) Referencia: RPL310P
Las especies Vibrio alginolyticus, Vibrio vulnificus y Vibrio parahaemolyticus pueden producir intoxicaciones alimentarias e infecciones graves en heridas.
Por ello, este kit es muy necesario para análisis de aguas de piscifactorías, ríos, cetareas, viveros, barcos, playas, piscinas y demás aguas naturales.
El kit se incuba antes de que transcurran 8 horas desde la inoculación, a 35 ºC durante 24 horas para los Vibrio halófilos.
El viraje del medio de azul oscuro a azul-verdoso es presuntivo, por lo que debe confirmarse aislando en TCBS Agar (MICROKIT DMT119, PPL048) y Vibrio Saline TSAT ISO 8914 (MICROKIT DMT172).
Las colonias verdes, azules y amarillas en TCBS y rojas en TSAT son de distintas especies patógenas de Vibrio, que se identificarán con kits adecuados (MICROKIT KBH262).
En TSAT, Vibrio parahaemolyticus crece con colonias de 2-3 mm y color rojo oscuro.
Confirmar con TSI Agar: Vibrio parahaemolyticus provoca pico rojo, fondo amarillo, sin ennegrecimiento ni gas.
Vibrio alginolyticus crece con colonias rojas o blancas, pero muy grandes y lobuladas.
Vibrio cholerae y V.vulnificus crecen con colonias incoloras-crema.
EL MÉTODO P/A (PRESENCIA AUSENCIA) Y RECUENTO NMP MEDIANTE LOS KITS P/A DE MICROKIT PARA TODOS LOS PARÁMETROS. NMP-RACKS
2-C Bis MICROKIT® P/A PARA LA DETECCION DE VIBRIO CHOLERAE EN 100 ML DE AGUA (Caldo TCBS modificado) Referencia: RPL312
Vibrio choleare es el agente causal del cólera, desgraciadamente cada vez más extendido en su cepa menos conocida y peligrosa a países desarrollados.
Otras muchas especies de Vibrio son inocuas y muy didácticas.
Este patógeno es frecuente en países tropicales y en la ruta de inmigración de africanos a Francia a través de España.
El kit se incuba 24 horas a 28 ºC, que es la temperatura ideal para este microorganismo, cuyo hábitat son los peces, de sangre fría. El viraje a amarillo es presuntivo de Vibrio cholerae.
Confirmar en Agar TCBS (DMT119, TPL503) e identificar las colonias con KBH262 y antisueros (ZM05, ZM06, ZM07, BAA001).
El servicio SEILAGUA 2002-2003 demuestra que este kit es infinitamente más sensible (ausencia total de falsos negativos) que el método MF en TCBS Agar (con 100% de falsos negativos!!!).
Sin embargo es poco específico, con frecuentes falsos positivos (por ej. E.coli), de ahi la necesidad de confirmar en placa:
A diferencia de las Enterobacterias, Vibrio cholerae es oxidasa positivo.
Como diferencia de los Coliformes, es lactosa negativo.
A diferencia de otros Vibrio, no crece con >6% (60 g/l) de ClNa.
NUEVO: V.cholerae P/A Cromogénico,
los positivos viran a rojizo (naranja, púrpura, ámbar) en 36h (y hasta en 5 dias para detectar los casos de estress extremo). Referencia: RPL312C
EL MÉTODO P/A (PRESENCIA AUSENCIA) Y RECUENTO NMP MEDIANTE LOS KITS P/A DE MICROKIT PARA TODOS LOS PARÁMETROS. NMP-RACKS
2-D MYCOKIT P/A PARA LA DETECCION DE HONGOS (LEVADURAS Y MOHOS) EN 100 ml DE AGUA (Caldo Rosa Bengala Cloranfenicol modificado) Referencia: RPL315

Izda: Mohos en superficie y fondo, Dcha: Levaduras enturbiando
Los laboratorios, industrias de refrescos y las aguas naturales pueden verse invadidas por distintas especies de hongos que a menudo son alterativas de las propiedades organolépticas de los productos fabricados.
Por ello, este kit resulta de gran interés en industria alimentaria y cosmética, sobre todo, así como en aguas de baños (hongos dermatofitos), como piscinas, playas, duchas…
Conviene que la muestra de agua sea de la superficie, sobre todo si hay espuma o suciedad, pues es ahí donde se acumulan estos microorganismos y sus esporas.
El kit se incuba a 21-25 ºC durante 3-7 días.
La turbidez demuestra presencia de levaduras, al ser el medio selectivo contra bacterias.
Los fieltros superficiales o floculantes indican presencia de mohos.
Si se desea, se pueden identificar las especies de levaduras (Rapid-Yeast) y de mohos (microscopio y claves MICROKIT).
Como control positivo puede utilizarse la cepa Candida albicans como levadura y Aspergillus niger como moho, en cómodas lentículas de MICROKIT.
Recomendamos asimismo la participación en servicios intercomparativos como SEILAGUAS FARMACOSMÉTICAS, para validar los procedimientos y los operarios.
NUEVO: MYCOKIT P/A Cromogénico,
los positivos viran a verde desde las primeras 48h (y hasta 3 dias para los más lentos). Ref: Viales FPA950 (no se puede elaborar en frascos preparados tomamuestras P/A)
EL MÉTODO P/A (PRESENCIA AUSENCIA) Y RECUENTO NMP MEDIANTE LOS KITS P/A DE MICROKIT PARA TODOS LOS PARÁMETROS. NMP-RACKS
2-E MICROKIT® P/A PARA LA DETECCION DE ESTAFILOCOCOS EN 100 ml DE AGUA (Caldo Mannitol hipersalino muy modificado) Referencia: RPL320
 La presencia de estafilococos en agua es muy frecuente en aguas de baño, que pueden quedar contaminadas por personas portadoras.
La presencia de estafilococos en agua es muy frecuente en aguas de baño, que pueden quedar contaminadas por personas portadoras.
Por ello, este kit es necesario para completar el análisis de aguas de piscinas, playas y baño en general, según la legislación actual, además de su interés en Laboratorios Farmacéuticos y cosméticos.
El kit se incuba a 37 ºC durante 24-48 horas.
La turbidez prueba la presencia de estafilococos.
El viraje de rojo a naranja o amarillo es presuntivo de presencia de Staphylococcus aureus, con cepas patógenas del hombre.
Dada la posible presencia de falsos positivos (y a pesar de la adición de numerosos agentes selectivos al caldo Mannitol, que se ha optimizado en Mayo de 2007 mediante la adición de más agentes reductores y parafina líquida, que disminuyen el nivel de falsos positivos de micrococos y otros aerobios halófilos)…
…confirmar estriando en Agar Baird Parker (MICROKIT DMT016, PPL002, TPL125, RPL003, MBN106)
y si aparecen colonias negras con borde blanco y halo, se trata de S. aureus;
o bien en Agar Mannitol (DMT078, TPL066, RPL023, PPL907…) y si aparecen colonias amarillas, se trata de S.aureus.
Confirmar si es cepa patógena con la prueba de la coagulasa (MICROKIT KWD094).
El servicio SEILAGUA 2002-2003 demostró que este kit, incluso antes de su optimización de Mayo de 2007, es sumamente más sensible (ausencia total de falsos negativos) que el método MF en Baird Parker o en Mannitol Salt Agar (con 29% de falsos negativos!!!).
Sin embargo es poco específico, con frecuentes falsos positivos, de ahi la necesidad de confirmar estriando en placa selectiva.
Como control positivo puede utilizarse la cepa Staphylococcus aureus, en cómodas lentículas de MICROKIT.
Recomendamos asimismo la participación en servicios intercomparativos como SEILAGUAS FARMACOSMÉTICAS, para validar los procedimientos y los operarios.
Validación: En 7 años de intercomparación de 70 laboratorios de toda España en más de 700 muestras duplicadas, se demuestra comparado con filtración de membrana en el medio oficial (Baird Parker Agar y Mannitol Salt Agar)…
…una sensibilidad del 100% frente al 71,0% y al 60,0% respectivamente del método oficial,
así como una especificidad 96,0% frente al 65,0% y 83,0% respectivamente.
El límite de detección resulta un 70% más cercano a 1 ufc/100 ml que el del método oficial.
EL MÉTODO P/A (PRESENCIA AUSENCIA) Y RECUENTO NMP MEDIANTE LOS KITS P/A DE MICROKIT PARA TODOS LOS PARÁMETROS. NMP-RACKS
2-F FICOKIT (MICROKIT® P/A PARA LA DETECCION DE ALGAS MICROSCOPICAS EN 100 ml DE AGUA) (Caldo Algas Modificado) Referencia: RPL307
 Para la detección de todo tipo de algas microscópicas en aguas (Cianofíceas, Clorofíceas, Diatomeas, etc.), desarrollamos FICOKIT, test de presencia / ausencia en 100 ml de muestra.
Para la detección de todo tipo de algas microscópicas en aguas (Cianofíceas, Clorofíceas, Diatomeas, etc.), desarrollamos FICOKIT, test de presencia / ausencia en 100 ml de muestra.
De gran interés en acuicultura, piscinas, aguas envasadas, aguas naturales, aguas de refrigeración y lavado, etc,
FICOKIT contiene un caldo de cultivo especialmente formulado para microorganismos fotosintéticos en general, a alta concentración, estéril y listo para su uso,
al que se han añadido agentes que aceleran el crecimiento vegetal.
Tomar la muestra de agua (50‑100 ml) rascando las superficies bañadas por la misma y agitando.
Es recomendable que la muestra sea lo más representativa posible, por lo que pueden añadirse pequeños trozos del medio ambiente cercano
y, si el agua de muestra es muy limpia, un filtro enrollado de 0,45 um de poro por el que se hayan filtrado 5 litros o más del agua de muestra.
Pero siempre añadiendo directamente al kit un mínimo de 50 ml de agua, ya que el medio está a alta concentración y un máximo de 100 ml de agua, ya que hay que dejar una cámara de aire.
Incubar junto a una ventana con cortina traslúcida donde no incida directamente la luz del sol,
durante 2‑30 días (los resultados serán siempre más rápidos en primavera, dado el fotoperiodo ideal).
La temperatura ambiente ideal es de 21‑25 ºC.
Sobre todo en lugares poco soleados y en invierno, pueden reproducirse artificialmente estas condiciones…
…con fotoperiodo de 16 horas de luz/8 horas de oscuridad
mediante fluorescentes de menos de 3.200 LUX situados a 4,5 metros de los frascos de FICOKIT.
La aparición de fieltros, mucosidades, filamentos o turbidez con los colores propios de la fotosíntesis (verde, verde azulado, verde amarillento, rojizo, pardo…), indica presencia de microorganismos fotosintéticos en la muestra.
Estos microorganismos alteran las propiedades organolépticas, producen limos obturadores y en algunos casos (cianobacterias) son tóxicos.
Solicite con su pedido de FICOKIT las claves de microalgas MICROKIT para diferenciar cianofíceas, clorofíceas, diatomeas, etc. al microscopio y poder identificar incluso a nivel de géneros.
Como control positivo puede pedir a MICROKIT la cepa Chlorella vulgaris.
No se pierda nuestro video de Ficokit y Cianokit:
https://www.youtube.com/watch?v=TZYC3ZKcSQM&t=252s
EL MÉTODO P/A (PRESENCIA AUSENCIA) Y RECUENTO NMP MEDIANTE LOS KITS P/A DE MICROKIT PARA TODOS LOS PARÁMETROS. NMP-RACKS
2-G CIANOKIT (MICROKIT® P/A PARA LA DETECCION DE ALGAS CIANOFICEAS O CIANOBACTERIAS Y OTRAS BACTERIAS FOTOSINTETICAS EN 100 ml DE AGUA) (Caldo Algas con suplemento para cianobacterias) Referencia: RPL306
De gran interés para acuicultura, piscinas, aguas minerales, aguas estancadas, aguas de abastecimiento, etc., este kit diseñado por MICROKIT, contiene un medio de cultivo especial para cianofíceas, estéril y listo para su uso.
Las cianofíceas/cianobacterias son algas/bacterias muy primitivas que pueden provocar problemas de toxicidad en las aguas donde proliferan.
Oscillatoria erythraea, especie planctónica marina, produce una toxina mortal para los peces, cuando su concentración es elevada, y que intoxica la cadena alimenticia, pudiendo ser mortal para el hombre (enfermedad tropical «ciguatera»).
Lyngbya majuscula puede provocar dermatitis necrótica a los bañistas de playas contaminadas por ella.
En aguas continentales, sobre todo, Aphanizomenon flos-aquae, Anabaena flos-aquae, Schizothrix calcicola, Lyngybya gracilis, Oscillatoria nigroviridis, Calothrix crustacea, Nostoc muscorum, Symploca muscorum, Tolypothrix byssoidea y Microcoleus lyngbyaceus son varias especies que se ha comprobado producen una amplia gama de cianotoxinas.
Anabaena circinalis, Symploca hydroides y algunas especies de Microcystis, provocan dermatitis por simple baño en aguas donde proliferan.
Recientemente Paul R. Hunter (Sept.1995, Cyanobacteria in fresh waters, Microbiology Europe Vol. 3, Nº 5) recopila los ultimos casos de mayor relevancia internacional,
con dolor de cabeza, diarrea, vómitos, conjuntivitis, otitis, fiebre, urticaria, asma…
provocados en personas tras 2-48 horas del contacto
(a veces simple baño, ni siquiera consumo) con aguas donde se ha dado un bloom algal de cianofíceas en Inglaterra.
En cualquier caso, un agua con abundantes cianofíceas jamás debe ser consumida.
Incluso deben cerrarse las aguas con blooms de cianofíceas a las actividades recreativas, pues se han dado casos de neumonía a canoistas que navegaban sobre un bloom algal de Microcystis aeruginosa.
Se establece una clasificación de la polución de las aguas, en función de los grupos de cianocífeas existentes:
En aguas extremadamente polutas, proliferan especies de Spirulina y Anabaena.
En cambio en aguas polutas, proliferan especies de Oscillatoria y Phormidium.
Y en aguas moderadamente polutas, proliferan Anabaena flos-aquae, Aphanizomenon flos-aquae, y diversas especies de Nostoc y Oscillatoria.
Se consideran puras las aguas ricas en especies de la Stigonematácea Hapalosiphon.
En aguas estancadas de verano, sobre todo, las sustancias nitrogenadas se agotan y las cianofíceas, capaces de fijar nitrógeno atmosférico (con heterocistes, sobre todo), libres de competencia, proliferan.
Esto es más frecuente en aguas continentales que en aguas marinas.
Y cada vez más frecuente en aguas europeas, por el aporte fosfatado que proporcionan los vertidos de fertilizantes en agricultura.
Con CIANOKIT puede detectarse la presencia de cianofíceas antes de que sea demasiado tarde.
Con las claves de identificación de géneros de cianobacterias que pueden solicitarse a MICROKIT con sus pedidos de CIANOKIT, puede, además, avanzarse en el pronóstico de la toxicidad del agua.
Las algas acuáticas pueden encontrarse en superficie, flotando como NEUSTON (sus proliferaciones se denominan «flores de agua» y pueden crear anoxia en las aguas inferiores);
o bien en la masa de agua, formando el PLANCTON;
o bien adheridas a superficies y en el fondo, o BENTOS.
A menudo colorean el agua de diversos tonos azulados (cianofíceas),
rojos (dinofíceas-mareas rojas- y cianofíceas),
pardos (diatomeas)
o verde-amarillentos (clorofíceas) cuando se encuentran en grandes concentraciones.
Una buena recolección de muestras, debe incluir los tres tipos de hábitats descritos: El NEUSTON se recoge dejando entrar agua superficial en un bote, sin agitar. Si es visible se toma con pinzas.
El PLANCTON se puede coger con una red de 20-60µm de poro, aunque si su concentración es suficientemente alta, bastará con tomar una muestra de 250 ml en un frasco, entre dos aguas, sin agitar y sin rapidez.
El BENTOS se tomará rascando la superficie sólida con una navaja o pasando un tubo de recolección suavemente por la zona superficial del sedimento.
Sembrar cada tipo de muestra (Neuston, Plancton y Bentos) en un frasco de CIANOKIT.
El Plancton es preferible sembrarlo tras dejar sedimentar el frasco de muestra de 3 a 24 horas, y tomando la muestra del fondo con una pipeta o jeringa.
Dejar una buena cámara de aire (medio frasco). Cerrar. Agitar para mezclar la muestra con el medio de cultivo.
La incubación se realizará junto a una ventana.
En zonas poco soleadas y en invierno, se hará mejor en una habitación con una temperatura de 20ºC,
con fluorescentes de luz blanca fría, situados a 4’5 metros de los frascos (intensidad jamás superior a 3.200 LUX),
con un fotoperiodo de 16 horas de luz/8 horas de oscuridad,
durante 2-30 días.
Nunca se debe dejar que la luz directa del sol incida sobre los frascos, aunque si es indirecta ayudará a acelerar los resultados.
Debe realizarse, al menos, un análisis semanal, para que la prevención sea eficaz.
Las cianofíceas se denominan también «algas azules», pero muchas especies son verdes, rojas, violetas, negras…
Cualquiera de estos colores, desarrollado en el líquido o en las paredes y fondo de CIANOKIT, son indicadores de presencia de cianofíceas,
independientemente del aspecto afieltrado, mucoso, turbio o filamentoso que pueda adquirir.
Debe confirmarse al microscopio, pues otras algas pueden dar lugar a falsos positivos.
Otras bacterias fotosintéticas también pueden proliferar en CIANOKIT, aunque es difícil porque precisan las condiciones anaerobias que consiguen en los sedimentos de los lagos.
NOTA: PARA RECUENTO, UTILICE EL MEDIO DESHIDRATADO O LAS PLAQUIS® HERMETICAS DE CIANAGAR.
Control de calidad positivo: Pida el mix e cianobacterias de MICROKIT.
https://www.microkit.es/fichas/PRESENCIA-AUSENCIA-KITS-INTRODUCCION.pdf
EL MÉTODO P/A (PRESENCIA AUSENCIA) Y RECUENTO NMP MEDIANTE LOS KITS P/A DE MICROKIT PARA TODOS LOS PARÁMETROS. NMP-RACKS
PUEDE CONVERTIR TODOS LOS KITS P/A DE MICROKIT EN RECUENTO NMP GRACIAS A LAS CUBETAS NMP-RACKS https://www.microkit.es/fichas/MPN-RACK.pdf
El usuario final es el único responsable de la destrucción de los microorganismos que se hayan multiplicado en el interior de cada frasco, de acuerdo con la legislación medioambiental vigente. Añada cloro o lejía hasta el borde, con cuidado de no tocar ni derramar el cultivo, antes de desechar a la basura. Si al abrir los botes sale gas a presión o líquido y se salpica, lavar las manos con agua corriente y jabón.
¿Necesita asesoría sobre los kits y formatos (frascos, viales o botes) que se adaptan mejor a su caso? consulte en el email consultastecnicas@microkit.es
Si desea más información sobre nuestros KITS P/A, póngase en contacto con nosotros a través de nuestro correo electrónico microkit@microkit.es
Haga sus pedidos de kits P/A en pedidos@mirokit.es
https://www.microkit.es/monograficos/21-Monograf–a-M–todos-alternativos-en-Control-microbiol–gico-de-aguas.pdf1
No se pierda nuestro vídeo de los viales P/A:
https://youtu.be/6OfsD7zU_8U